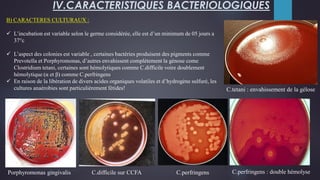
B) CARACTERES CULTURAUX :
 L’incubation est variable selon le germe considérée, elle est d’un minimum de 05 jours a
37°c
 L’aspect des colonies est variable , certaines bactéries produisent des pigments comme
Prevotella et Porphyromonas, d’autres envahissent complètement la génose come
Clostridium tetani, certaines sont hémolytiques comme C.difficile voire doublement
hémolytique (α et β) comme C.perfringens
 En raison de la libération de divers acides organiques volatiles et d’hydrogène sulfuré, les
cultures anaérobies sont particulièrement fétides!
IV.CARACTERISTIQUES BACTERIOLOGIQUES
C.tetani : envahissement de la gélose
Porphyromonas gingivalis C.difficile sur CCFA C.perfringens C.perfringens : double hémolyse
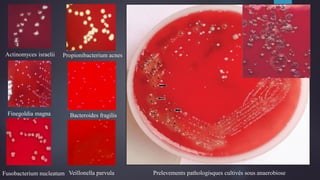
Actinomyces israelii Propionibacterium acnes
Finegoldia magna
Veillonella parvula
Bacteroides fragilis
Fusobacterium nucleatum Prelevements pathologisques cultivés sous anaerobiose

Le document porte sur les bactéries anaérobies strictes, leur classification, caractéristiques, et facteurs de pathogénicité. Il aborde également les méthodes de diagnostic et de prévention des infections, soulignant la difficulté de leur identification due à leur nature. En conclusion, il met en avant leur rôle croissant dans les maladies infectieuses et les défis associés à leur traitement.